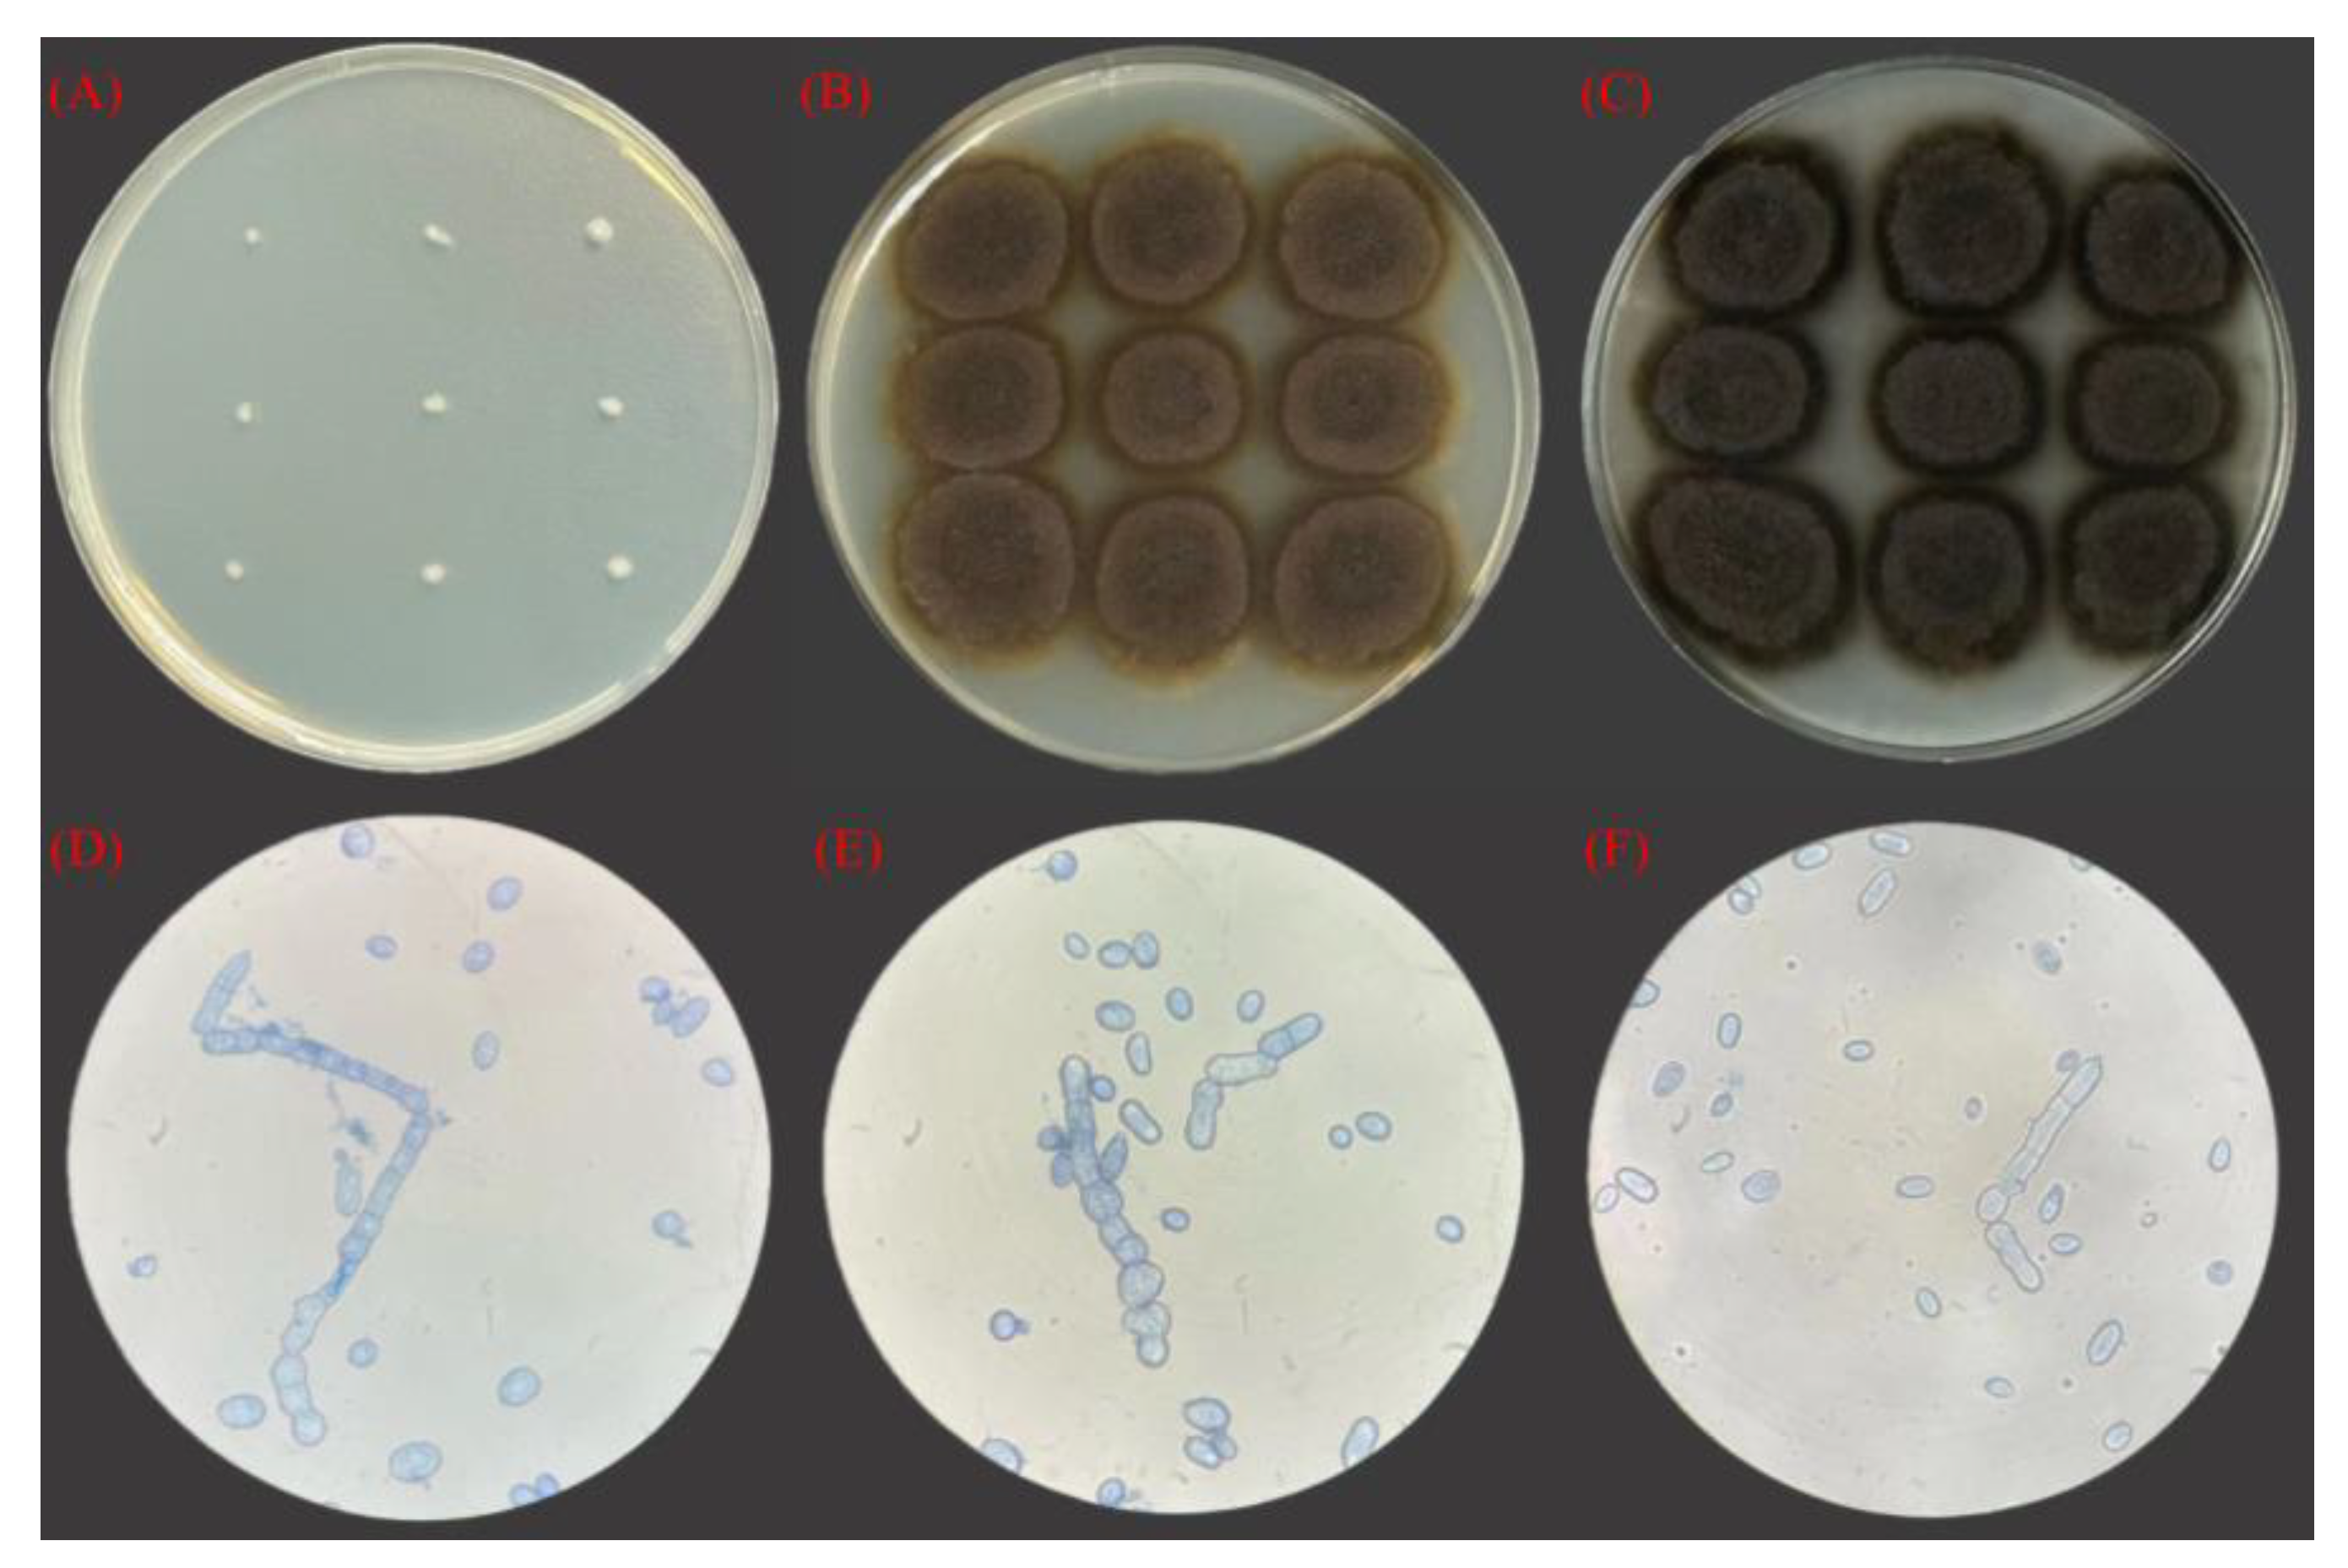
Foods 13 03063 g002

Investigation into the Production of Melanin from By-Products of Huangjiu Brewing
Abstract
1. Introduction
2. Materials and Methods
2.1. Sampling and Processing
2.2. Isolation and Culture of Strains
2.3. Screening of High-Yield Melanin Strains
2.4. Growth Curve Drawing and Morphological Characteristics Observation of Strains
2.5. Molecular Biological Identification of Strains
2.6. Extraction and Determination of Fermentation Products
2.7. Optimization of Fermentation Conditions of Aureobasidium pullulans
2.8. Determination of Main Components of Huangjiu Lees
2.9. Adaptive Evolution of Aureobasidium pullulans
2.10. Optimization of Fermentation Strategy for Huangjiu Lees
2.11. Statistical Analysis
3. Results and Discussion
3.1. Identification of Melanin-Producing Strains
3.2. Plotting of the Growth Curve of Strain 53LC7
3.3. Morphological Characteristics of Strains
3.4. Molecular Biological Identification and Phylogenetic Tree Construction
3.5. Optimization of Fermentation Conditions for Aureobasidium pullulans 53LC7
3.5.1. Effect of Fermentation Conditions
3.5.2. Optimization of Melanin Fermentation Process by Response Surface Method
3.6. The Main Ingredient of Huangjiu Lees
3.7. Adaptive Evolution
3.7.1. Comparison of Adaptive Evolutionary Strains
3.7.2. Comparison of Key Gene Expression
3.8. Optimization of Fermentation Strategy for Production of Melanin in Huangjiu Lees
3.8.1. Study on Fermentation of Huangjiu Lees Treated with Cellulase
3.8.2. Investigation of Pullulanase-Assisted Treatment for Increased Melanin Production
4. Conclusions
Supplementary Materials
Author Contributions
Funding
Institutional Review Board Statement
Informed Consent Statement
Data Availability Statement
Conflicts of Interest
References
- Cai, H.Y.; Zhang, T.; Zhang, Q.; Luo, J.; Cai, C.G.; Mao, J.W. Microbial Diversity and Chemical Analysis of the Starters Used in Traditional Chinese Sweet Rice Wine. Food Microbiol. 2018, 73, 319–326. [Google Scholar] [CrossRef] [PubMed]
- Huang, Z.R.; Guo, W.L.; Zhou, W.B.; Li, L.; Xu, J.X.; Hong, J.L.; Liu, H.P.; Zeng, F.; Bai, W.D.; Liu, B.; et al. Microbial Communities and Volatile Metabolites in Different Traditional Fermentation Starters Used for Hong Qu Glutinous Rice Wine. Food Res. Int. 2019, 121, 593–603. [Google Scholar] [CrossRef] [PubMed]
- Tian, S.F.; Zeng, W.Z.; Fang, F.; Zhou, J.W.; Du, G.C. The Microbiome of Chinese Rice Wine (Huangjiu). Curr. Res. Food Sci. 2022, 5, 325–335. [Google Scholar] [CrossRef]
- Yu, H.Y.; Xie, T.; Xie, J.R.; Ai, L.Z.; Tian, H.X. Characterization of Key Aroma Compounds in Chinese Rice Wine Using Gas Chromatography–Mass Spectrometry and Gas Chromatography–Olfactometry. Food Chem. 2019, 293, 8–14. [Google Scholar] [CrossRef]
- Ji, Z.W.; Mao, J.Q.; Chen, S.G.; Mao, J. Antioxidant and Anti-Inflammatory Activity of Peptides from Foxtail Millet (Setaria Italica) Prolamins in HaCaT Cells and RAW264.7 Murine Macrophages. Food Biosci. 2020, 36, 100636. [Google Scholar] [CrossRef]
- Zhang, D.Y.; Xu, X.L.; Xie, G.F. Utilization of Functional Components in Huangjiu Lees: A Review. Food Ferment. Ind. 2023, 49, 332–338. [Google Scholar] [CrossRef]
- Zhang, R.B.; Liu, Y.Z.; Liu, S.P.; Mao, J. The Existing Recovery Approaches of the Huangjiu Lees and the Future Prospects: A Mini Review. Bioengineering 2022, 9, 695. [Google Scholar] [CrossRef]
- Yao, K.Y.; Wei, Z.H.; Xie, Y.Y.; Wang, D.M.; Liu, H.Y.; Fang, D.; Ma, M.R.; Liu, J.X. Lactation Performance and Nitrogen Utilization of Dairy Cows on Diets Including Unfermented or Fermented Yellow Wine Lees Mix. Livest. Sci. 2020, 236, 104025. [Google Scholar] [CrossRef]
- Butler, M.J.; Day, A.W. Fungal Melanins: A Review. Can. J. Microbiol. 1998, 44, 1115–1136. [Google Scholar] [CrossRef]
- Aghajanyan, A.E.; Hambardzumyan, A.A.; Hovsepyan, A.S.; Asaturian, R.A.; Vardanyan, A.A.; Saghiyan, A.A. Isolation, Purification and Physicochemical Characterization of Water-Soluble Bacillus thuringiensis Melanin. Pigment Cell Res. 2005, 18, 130–135. [Google Scholar] [CrossRef]
- Langfelder, K.; Streibel, M.; Jahn, B.; Haase, G.; Brakhage, A.A. Biosynthesis of Fungal Melanins and Their Importance for Human Pathogenic Fungi. Fungal Genet. Biol. 2003, 38, 143–158. [Google Scholar] [CrossRef]
- Menter, J.M.; Willis, I. Electron Transfer and Photoprotective Properties of Melanins in Solution. Pigment Cell Res. 1997, 10, 214–217. [Google Scholar] [CrossRef] [PubMed]
- Romero-Martinez, R.; Wheeler, M.B.; Guerrero-Plata, A.; Rico, G.; Torres-Guerrero, H. Biosynthesis and Functions of Melanin in Sporothrix schenckii. Infect. Immun. 2000, 68, 3696–3703. [Google Scholar] [CrossRef]
- Buszman, E.; Pilawa, B.; Zdybel, M.; Wilczyński, S.; Gondzik, A.; Witoszyńska, T.; Wilczok, T. EPR Examination of Zn2+ and Cu2+ Binding by Pigmented Soil Fungi Cladosporium cladosporioides. Sci. Total Environ. 2006, 363, 195–205. [Google Scholar] [CrossRef]
- Matuszczyk, M.; Buszman, E.; Pilawa, B.; Witoszyńska, T.; Wilczok, T. Cd2+ Effect on Free Radicals in Cladosporium cladosporioides-Melanin Tested by EPR Spectroscopy. Chem. Phys. Lett. 2004, 394, 366–371. [Google Scholar] [CrossRef]
- Zdybel, M.; Pilawa, B.; Buszman, E.; Zdybel, M.; Pilawa, B. EPR Studies of Cladosporium cladosporioides Complexes with Amphotericin B. Nukleonika 2013, 58, 401–405. [Google Scholar] [CrossRef]
- Prota, G. ChemInform Abstract: Progress in the Chemistry of Melanins and Related Metabolites. ChemInform 1989, 20, 525–556. [Google Scholar] [CrossRef]
- Saxena, D.; Ben-Dov, E.; Manasherob, R.; Barak, Z.; Boussiba, S.; Zaritsky, A. A UV Tolerant Mutant of Bacillus Thuringiensis Subsp. Kurstaki Producing Melanin. Curr. Microbiol. 2002, 44, 25–30. [Google Scholar] [CrossRef]
- Patel, K.; Wyman, J.A.; Patel, K.; Burden, B. A Mutant of Bacillus thuringiensis Producing a Dark-Brown Pigment with Increased UV Resistance and Insecticidal Activity. J. Invertebr. Pathol. 1996, 67, 120–124. [Google Scholar] [CrossRef]
- Hung, Y.C.; Sava, V.; Hong, M.Y.; Huang, G.S. Inhibitory Effects on Phospholipase A2 and Antivenin Activity of Melanin Extracted from Thea sinensis Linn. Life Sci. 2004, 74, 2037–2047. [Google Scholar] [CrossRef]
- Hung, Y.C.; Sava, V.M.; Makan, S.Y.; Hong, M.Y.; Steven, G. Huang Preventive Effect of Thea sinensis Melanin against Acetaminophen-Induced Hepatic Injury in Mice. J. Agric. Food Chem. 2004, 52, 5284–5289. [Google Scholar] [CrossRef] [PubMed]
- Huang, L.; Liu, M.Y.; Huang, H.Y.; Wen, Y.Q.; Zhang, X.Y.; Wei, Y. Recent Advances and Progress on Melanin-like Materials and Their Biomedical Applications. Biomacromolecules 2018, 19, 1858–1868. [Google Scholar] [CrossRef] [PubMed]
- Tran-Ly, A.N.; Reyes, C.; Schwarze, F.W.M.R.; Ribera, J. Microbial Production of Melanin and Its Various Applications. World J. Microbiol. Biotechnol. 2020, 36, 170. [Google Scholar] [CrossRef]
- Lee, J.H.; Hyun, C.K. Insulin-Sensitizing and Beneficial Lipid-Metabolic Effects of the Water-Soluble Melanin Complex Extracted FromInonotus Obliquus. Phytother. Res. 2014, 28, 1320–1328. [Google Scholar] [CrossRef]
- Kang, C.C.; Hao, L.M.; Zhang, L.M.; Zheng, Z.Q.; Yang, Y.W. Isolation, Purification and Antioxidant Activity of Polysaccharides from the Leaves of Maca (Lepidium meyenii). Int. J. Biol. Macromol. 2018, 107, 2611–2619. [Google Scholar] [CrossRef]
- Manitchotpisit, P.; Skory, C.D.; Peterson, S.W.; Price, N.P.J.; Vermillion, K.E.; Leathers, T.D. Poly (β-L-Malic Acid) Production by Diverse Phylogenetic Clades of Aureobasidium pullulans. J. Ind. Microbiol. Biotechnol. 2012, 39, 125–132. [Google Scholar] [CrossRef]
- Tarabasz-Szymańska, L.; Galas, E. Two-Step Mutagenesis of Pullularia Pullulans Leading to Clones Producing Pure Pullulan with High Yield. Enzym. Microb. Technol. 1993, 15, 317–320. [Google Scholar] [CrossRef]
- Lin, C.Y.; Zhang, K.; Zhao, S.S.; Wang, W.; Ru, X.; Song, J.Z.; Cong, H.; Yang, Q. Screening and Identification of a Strain of Aureobasidium pullulans and Its Application in Potato Starch Industrial Waste. Environ. Res. 2022, 214, 113947. [Google Scholar] [CrossRef] [PubMed]
- Zhang, K.; Lin, C.Y.; Zhao, S.S.; Wang, W.; Zhou, W.; Ru, X.; Cong, H.; Yang, Q. The Role of pH Transcription Factor Appacc in Upregulation of Pullulan Biosynthesis in Aureobasidium pullulans Using Potato Waste as a Substrate. Int. J. Biol. Macromol. 2023, 242, 124797. [Google Scholar] [CrossRef]
- Liu, F.X.; Ren, J.; Guo, L.; Liu, Y.; Li, D.F.; Yu, B. Desymmetric Hydrolysis of Prochiral Imide for S-Pregabalin Synthesis by Rationally Designed D-Hydantoinase. Green Chem. 2022, 24, 4748–4753. [Google Scholar] [CrossRef]
- Peng, L.; Kong, X.Y.; Wang, Z.M.; Ai-lati, A.; Ji, Z.W.; Mao, J. Baijiu Vinasse as a New Source of Bioactive Peptides with Antioxidant and Anti-Inflammatory Activity. Food Chem. 2021, 339, 128159. [Google Scholar] [CrossRef] [PubMed]
- Zhang, Y.; Feng, J.; Wang, P.; Xia, J.; Li, X.R.; Zou, X. CRISPR/Cas9-Mediated Efficient Genome Editing via Protoplast-Based Transformation in Yeast-like Fungus Aureobasidium pullulans. Gene 2019, 709, 8–16. [Google Scholar] [CrossRef] [PubMed]
- Zhu, W.Z.; He, Q.Y.; Gao, H.; Nitayavardhana, S.; Khanal, S.K.; Xie, L. Bioconversion of Yellow Wine Wastes into Microbial Protein via Mixed Yeast-Fungus Cultures. Bioresour. Technol. 2020, 299, 122565. [Google Scholar] [CrossRef] [PubMed]
- Singh, R.S.; Saini, G.K.; Kennedy, J.F. Pullulan: Microbial Sources, Production and Applications. Carbohydr. Polym. 2008, 73, 515–531. [Google Scholar] [CrossRef]
- Engelberg, D.; Perlman, R.; Levitzki, A. Transmembrane Signaling in Saccharomyces cerevisiae as a Model for Signaling in Metazoans: State of the Art after 25 years. Cell. Signal. 2014, 26, 2865–2878. [Google Scholar] [CrossRef]

| Single Factor | Variable |
|---|---|
| Initial pH | 5.0, 5.5, 6.0, 6.5, 7.0 |
| Temperature (°C) | 24, 26, 28, 30, 32 |
| Fermentation time (d) | 3, 4, 5, 6, 7 |
| Rotational speed (rpm) | 140, 160, 180, 200, 220 |
| Inoculation quantity (%) | 1.0, 1.5, 2.0, 2.5, 3.0 |
| Horizontal | A: Initial pH | B: Temperature (°C) | C: Fermentation Time (d) | D: Inoculation Quantity (%) |
|---|---|---|---|---|
| −1 | 5.0 | 26 | 5 | 1.5 |
| 0 | 5.5 | 28 | 6 | 2.0 |
| 1 | 6.0 | 30 | 7 | 2.5 |
| Strain | Color | Melanin Yield (g/L) | Color Value |
|---|---|---|---|
| 53LC2 | black | 15.99 ± 1.02 | 97 |
| 53LC5 | black | 15.31 ± 0.99 | 92 |
| 53LC7 | black | 17.88 ± 1.22 | 118 |
| 53LC8 | dark green | 8.09 ± 0.92 | 58 |
| 53LCX | black | 14.89 ± 1.34 | 90 |
| 53LCY | black | 16.39 ± 0.26 | 99 |
Disclaimer/Publisher’s Note: The statements, opinions and data contained in all publications are solely those of the individual author(s) and contributor(s) and not of MDPI and/or the editor(s). MDPI and/or the editor(s) disclaim responsibility for any injury to people or property resulting from any ideas, methods, instructions or products referred to in the content. |
© 2024 by the authors. Licensee MDPI, Basel, Switzerland. This article is an open access article distributed under the terms and conditions of the Creative Commons Attribution (CC BY) license (https://creativecommons.org/licenses/by/4.0/).
Share and Cite
Lin, C.; Lu, P.; Ma, J.; Kan, T.; Han, X.; Liu, S.; Ji, Z.; Mao, J. Investigation into the Production of Melanin from By-Products of Huangjiu Brewing. Foods 2024, 13, 3063. https://doi.org/10.3390/foods13193063
Lin C, Lu P, Ma J, Kan T, Han X, Liu S, Ji Z, Mao J. Investigation into the Production of Melanin from By-Products of Huangjiu Brewing. Foods. 2024; 13(19):3063. https://doi.org/10.3390/foods13193063
Chicago/Turabian StyleLin, Congyu, Peiqi Lu, Jingqiu Ma, Tao Kan, Xiao Han, Shuangping Liu, Zhongwei Ji, and Jian Mao. 2024. "Investigation into the Production of Melanin from By-Products of Huangjiu Brewing" Foods 13, no. 19: 3063. https://doi.org/10.3390/foods13193063
APA StyleLin, C., Lu, P., Ma, J., Kan, T., Han, X., Liu, S., Ji, Z., & Mao, J. (2024). Investigation into the Production of Melanin from By-Products of Huangjiu Brewing. Foods, 13(19), 3063. https://doi.org/10.3390/foods13193063

